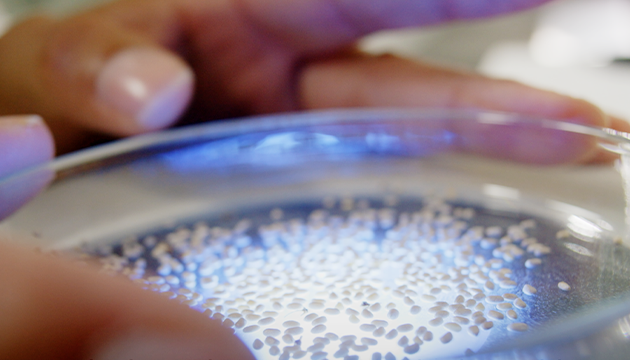

さぁ、自活肌へ。
目指したのは、肌が本来持っている“自らを守りダメージを修復するチカラ”を、しっかりと発揮できる「自活肌」。
これまで、肌に足りていないものを“補うケア”が一般的でした
新しいアーティストリーが着目したのは、肌悩みに応じた“補うケア”の前に、まず「健康な肌を育む」というヘルシービューティ発想です。
さぁ、自活肌へ。
目指したのは、肌が本来持っている“自らを守りダメージを修復するチカラ”を、しっかりと発揮できる「自活肌」。
これまで、肌に足りていないものを“補うケア”が一般的でした
新しいアーティストリーが着目したのは、肌悩みに応じた“補うケア”の前に、まず「健康な肌を育む」というヘルシービューティ発想です。
5つの機能が備わっていることが、
「自活肌」のカギという発見。
種から美肌へ。
植物の生命力で
美肌を科学する
ホワイトチアシードの驚異の力
VIEW MORE

アーティストリーは、植物の力で人々の健康をサポートする研究を80年以上も行ってきた植物栄養学のエキスパートである「ニュートリライト™」と手を組み、7,824種もの植物を研究し、肌に有用性の高い植物にたどり着きました。

古代から「魔法の種」と崇められてきた:チアシード
スーパーフードとして知られ、強力な活性酸素吸収力、美肌菌の働きのサポート、肌の細胞間脂質を補って肌にうるおいを与えるなど、肌の健康をサポートする「魔法の種」です。

93,888回もの試験を重ね、9年以上を費やし、ニュートリライトの創始者である「カール・レンボーグ」の名を冠した「レンボーグ・チア変種」という新しい種類のチアを生み出し、アメリカ特許を取得しています。

この「レンボーグ・チア変種」は、自社所有のオーガニック農場での種植えの段階から始まり、栽培、収穫、収穫した種子の運搬、加工、製品化まで、すべてのプロセスが、原料の種までさかのぼって追跡可能となっています。
「レンボーグ・チア変種」の全てを有効に活用するため、オイル、ジェル、エキス、パウダーまで、それぞれ最適な方法で抽出し、製品に配合。 種から肌へ。究極のものづくりへのこだわりが、一粒のチアシードに込められています。
敏感肌を含むすべての
肌タイプの方のために。
こだわりの製品開発
安心安全への取り組み
VIEW MORE

安全な製品は、安全な原材料から始まります。すべての原料供給業者を徹底的に調査し、当社の厳格な品質・安全基準を満たした業者からのみ原料を受け入れています。
アムウェイ製品に含まれるすべての原料は、アムウェイのトキシコロジスト(毒性学者)によって評価され、安全性が確認されたものを使用しています。

製品が完成したら、研究室でテストを行います。皮膚や目への刺激など、起こりうるあらゆる問題について専門家がテストし、安全性データベースには、さまざまな処方反応に関する情報が含まれ、蓄積されていきます。

発売前に敏感肌の被験者で実使用テストを行い、肌にトラブルが起きないことを確認して製品化※をしています。また、スキンNTの代表的な製品では日本でも敏感肌の被験者を含む実使用テストを実施。発売後もみなさまからのフィードバックを通じて、製品の安全性をモニターし続けています。
※一部の製品を除く
ご注意
UVプロテクトミルク、フレッシュ エッセンス アドバンスト、スリーピング マスクに関しては敏感肌訴求の対象外となります。コミュニケーションの際はご注意ください。
アーティストリー ヘルシースキン プログラム
健康美肌へ、まずは30日間。
¥13,280(税込)
アーティストリー スキンNT™ ザ・セラム エッセンシャル
無敵の健康美。今始める、未来のためのプレエイジングケア※1美容液。
¥11,990(税込)
アーティストリー スキンNT™ ザ・セラム スーペリア
無敵の健康美。手応えある本格エイジングケア※1美容液。
¥15,890(税込)
アーティストリー スキン NT™ スリーピング マスク
寝不足の肌悩みに着目 目覚めるたびに。まるで熟睡美肌へ
¥9,180(税込)
アーティストリー スキン NT™ UVプロテクトミルク
美容効果を一日中。エステのごとくケアする高機能美肌UV。
¥6,680(税込)
アーティストリー スキン NT™ フレッシュ エッセンス アドバンスト
現代の5大肌悩みに着目。マルチタスク美容液で全方位ケア。
¥8,650(税込)
アーティストリースキン NT™ クレンジングウォーター
頑固なメイクもPM2.5などの大気汚れも、磁石のように吸着してオフ!
¥4,140(税込)
アーティストリースキン NT™ クレンジングクリーム
美容成分たっぷり、贅沢でやわらかなクレンジングクリーム
¥5,570(税込)
アーティストリースキン NT™ クレンジングオイル
6種の植物由来オイルをブレンド、リッチなクレンジングオイル
¥6,410(税込)
アーティストリースキン NT™ さっぱりフェイスウォッシュ
うるおいを守りながら、すっきり素肌に洗い上げるジェル状洗顔料。
¥4,410(税込)
アーティストリースキン NT™ しっとりフェイスウォッシュ
しっとり吸い付くツヤ肌へ、泡で洗い上げる洗顔フォーム。
¥5,660(税込)
アーティストリースキン NT™ ハリフェイスウォッシュ
吸い付くような、もっちり肌に洗いあげる洗顔フォーム
¥5,950(税込)
アーティストリースキン NT™ さっぱりローション
うるおいと皮脂バランスに着目、さらさら肌に導くフルフル化粧水。
¥4,890(税込)
アーティストリースキン NT™ しっとりローション
うるおいをゴクゴク飲み干すように角層まで瞬時に浸透。しっとりツヤ肌へ導く化粧水。
¥5,350(税込)
アーティストリースキン NT™ ハリローション
うるおいを抱え込み、もっちりしたハリ肌をかなえる化粧水
¥7,330(税込)
アーティストリースキン NT™ ハリミルキーエマルジョン
エイジングサインが気になる肌に、長時間うるおいが続く乳液
¥8,600(税込)
アーティストリースキン NT™ ハリクリーム
エイジングサインに着目、吸いつくような感触に導くクリーム
¥12,970(税込)
アーティストリースキン NT™ ハリアイクリーム
目元のエイジングサインを見逃さず集中ケア、アイクリーム
¥7,720(税込)
アーティストリースキン NT™ ひきしめクリーム
年齢を重ねた肌を引き締めて、いきいきしたハリを与えてリフト感を。濃密クリーム
¥14,370(税込)
アーティストリースキン NT™ しっとりアイジェル
ツヤ感あるアイジェルで、なめらかな、うるおい目元へ。
¥6,120(税込)
アーティストリースキン NT™ さっぱりモイスチャージェル
余分な皮脂やテカリを抑え、うるおい続くひんやり保湿ジェル。
¥5,950(税込)
アーティストリースキン NT™ しっとりモイスチャージェル
24時間うるおい続く、みずみずしいジェルクリーム。
¥7,490(税込)
シリーズからアイテムを探す